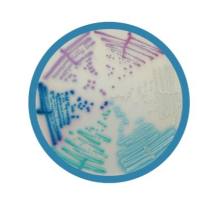
Chromagar法国科玛嘉 显色培养基，增补剂，预制平板，选择性培养基

相关产品推荐更多 >
万千商家帮你免费找货
0 人在求购买到急需产品
- 详细信息
- 技术资料
- 库存:
99
- 现货状态:
现货
- 供应商:
北京诺博莱德科技有限公司
硕华 530051无菌采样袋,304*114mm,810ml
产品货号:530051
产品名称:无菌采样袋,304*114mm,810ml
产品规格:500个/盒,2盒/箱
产品特点
▶ 自带光源,红外线读码,识别率高
▶单管解码仪USB接口即插即用
▶操作方便,单手持管读取底部二维码
▶高精度摄像头,识别二维码更精准
产品订购信息:
530051无菌采样袋,304*114mm,810ml,500个/盒,2盒/箱
|
货号 |
名称 |
规格 |
|
530011 |
无菌采样袋,127*76mm,60ml |
500个/盒,2盒/箱 |
|
530021 |
无菌采样袋,178*76mm,120ml |
500个/盒,2盒/箱 |
|
530031 |
无菌采样袋,229*114mm,540ml |
500个/盒,2盒/箱 |
|
530041 |
无菌采样袋,229*140mm,720ml |
500个/盒,2盒/箱 |
|
530051 |
无菌采样袋,304*114mm,810ml |
500个/盒,2盒/箱 |
|
530061 |
无菌采样袋,381*114mm,1080ml |
500个/盒,2盒/箱 |
|
530071 |
无菌采样袋,381*140mm,1260ml |
500个/盒,2盒/箱 |
|
530081 |
无菌采样袋,300*180mm,1650ml |
250个/盒,4盒/箱 |
|
530101 |
无菌采样袋,356*254mm,3000ml,铁丝加粗型 |
250个/盒,4盒/箱 |
|
530102 |
无菌采样袋,460*305mm,3000ml,铁丝加粗型 |
250个/盒,4盒/箱 |
|
531011 |
无菌采样袋,带书写区,127*76mm,60ml |
500个/盒,2盒/箱 |
|
531021 |
无菌采样袋,带书写区,178*76mm,120ml |
500个/盒,2盒/箱 |
|
531031 |
无菌采样袋,带书写区,229*114mm,540ml |
500个/盒,2盒/箱 |
|
531041 |
无菌采样袋,带书写区,229*140mm,720ml |
500个/盒,2盒/箱 |
|
531081 |
无菌采样袋,带书写区,300*180mm,1650ml |
250个/盒,4盒/箱 |
|
531131 |
无菌采样袋,带书写区, 229*114mm,540ml,铁丝加粗型 |
500个/盒,2盒/箱 |
|
531141 |
无菌采样袋,带书写区, 229*140mm,720ml,铁丝加粗型 |
500个/盒,2盒/箱 |
|
531181 |
无菌采样袋,带书写区, 300*180mm,1650ml,铁丝加粗型 |
250个/盒,4盒/箱 |
|
531191 |
无菌采样袋,带书写区, 254*254mm,1800ml,铁丝加粗型 |
250个/盒,4盒/箱 |
风险提示:丁香通仅作为第三方平台,为商家信息发布提供平台空间。用户咨询产品时请注意保护个人信息及财产安全,合理判断,谨慎选购商品,商家和用户对交易行为负责。对于医疗器械类产品,请先查证核实企业经营资质和医疗器械产品注册证情况。
技术资料暂无技术资料 索取技术资料